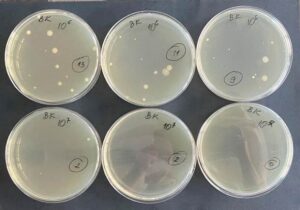
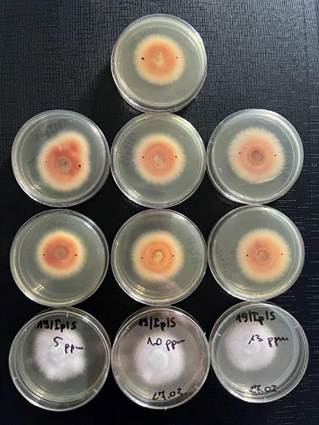

ETAP IV. Okres realizacji: od 01.01.2024 r. do 31.12.2024 r.
W etapie IV kontynuowano prace nad zastosowaniem wody ozonowanej w celu ograniczenia liczebności szkodników i mikroorganizmów w warunkach polowych w Garbcach i Biskupicach oraz na wypustkach w pakowalni w Poświętnie. Zakupiono wózek widłowy przeznaczony do kontaktu z żywnością, wykonano komorę do ozonowania, która usprawniła traktowanie szparagów wodą z ozonem, zmodernizowano opryskiwacz na podstawie obserwacji z I etapu operacji i zakupiono do niego lawetę, kupiono także beczkowóz usprawniający pracę na polu.
Prowadzono również testy laboratoryjne nad wpływem różnych dawek ozonu na wybrane gatunki szkodników i mikroorganizmów, oceniano fitotoksyczności ozonowanej wody dla roślin. Wykonany został monitoring nalotu owadów za pomocą pułapek zapachowych, białych lub zielonych kołków imitujących pędy szparagów pokryte lepem czy też roślin pułapkowych oraz monitoring występowania mikroorganizmów szkodliwych dla szparaga (fot. 1, fot. 2). Wykonano pomiary biometryczne wypustek i gałęziaków, obliczono plon, wykonano analizy chemiczne. Wykonano szczegółowe analizy zbiorowisk grzybów i bakterii obecnych zarówno na powierzchni jak i wewnątrz tkanek wypustek i gałęziaków. Wykonana została identyfikacja grzybów i bakterii do rodzaju lub gatunku metodami klasycznymi na podstawie cech morfologicznych (kształt, budowa ściany komórkowej, zdolność do wytwarzania przetrwalników) i biochemicznych kultur oraz metodami molekularnymi opartymi na analizie DNA.
W pakowalni w Poświętnie wykonano pomiary biometryczne wypustek w celu określenia cech, takich jak: masa jednostkowa, długość wypustki oraz średnica u podstawy i pod główką. Po potraktowaniu wypustek wodą ozonowaną, w tym samym dniu zmierzono poziom chlorofilu oraz parametry, które pozwalają ocenić poziom stresu w zebranych częściach jadalnych roślin. Wypustki szparaga z obiektu kontrolnego oraz moczone w wodzie ozonowanej przechowywane były w chłodni, w temperaturze 2ᵒC. Co 4 dni kontynuowane były pomiary parametrów stresu przy użyciu aparatu Opti – Sciences CCM300. Obliczono również ubytek masy wypustek. Takimi samymi badaniami objęto również wypustki zielone i białe zakupione od innych producentów. W Biskupicach, w okresie od sierpnia do września wykonano opryski plantacji szparaga wodą ozonowaną wytwarzanym bezpośrednio na polu, pestycydami, sama wodą, wodą ozonowaną z biopreparatem. Po opryskach określano liczebność agrofagów w każdej kombinacji metodą czerpakowania i odłowu na kołki pokryte klejem. Po zabiegu wykonano również odkrywki glebowe na głębokości 25 cm o wielkości 20×20 cm. Glebę przebrano ręcznie i z wykorzystaniem sita w celu identyfikacji szkodników.
Z przeprowadzonych badań polowych wynika, że plon handlowy uzyskany w 2024 r. w Garbcach był najwyższy w kombinacji doświadczenia, gdzie karpy przed wysadzeniem moczono w 1 ppm ozonowanej wodzie. Zwiększyła się tam liczba wypustek zebrana z 1 mb, ich średnica oraz masa jednostkowa. W 2024 r. stwierdzono też, że na obiektach, gdzie posadzono karpy ozonowane na 1 mb przypadało o 10,4% więcej gałęziaków, a rośliny charakteryzowały się przeciętnie o 24,2% większą liczbą gałęziaków niż w kontroli.
Wiosną 2024 r., po przezimowaniu roślin posadzonych w 2023 r. w Garbcach, stwierdzono w karpach nie traktowanych ozonem obniżoną zawartość cukrów w stosunku do ilości jesienią w roku poprzednim. Nie stwierdzono spadku zawartości cukrów (oprócz glukozy) w karpach ozonowanych. Obserwacje wykonane w Biskupicach na roślinach opryskiwanych pestycydem, wodą ozonowaną, roztworem biopestycydu w wodzie ozonowanej nie wykazały żadnych negatywnych zmian w porównaniu do kontroli. Gałęziaki były intensywnie zielone, bez przebarwień, chloroz lub nekroz. Nie stwierdzono więdnięcia lub zamierania gałęziaków pod wpływem oprysku. Gałęziaki roślin opryskanych wodą ozonowaną zawierały więcej azotu azotanowego, fosforu, chlorofilu i nieco więcej potasu w porównaniu z pozostałymi roślinami.
Na plantacjach w Garbcach i Biskupicach zaobserwowano typowe dla szparagów szkodniki, jednak liczebność ich populacji nie różniła się istotnie pomiędzy kombinacjami doświadczenia. Nie zauważono działania fitotoksycznego oprysków ozonowaną wodą na uprawę szparaga (fot. 4). Dominującymi w gatunkami występującymi na powierzchni i w wewnętrznych tkankach uprawianych roślin (wypustki i gałęziaki) były grzyby rodzajów Fusarium i Penicillium. Nie stwierdzono istotnych zmian w składzie gatunkowym grzybów uzyskanych w roślin traktowanych wodą ozonowaną i nieozonowaną. Mimo iż ozon zawarty w wodzie nie ma bezpośredniego biobójczego wpływu na grzyby, to wykazuje jednak oddziaływanie fizjologiczne. Niskie dawki ozonu 1-2 ppm stymulowały procesy odpornościowe u roślin, między innymi zmieniając poziom polifenoli, co ma wpływ na zmianę składu gatunkowego w zbiorowiskach grzybów i bakterii. Zwiększa się konkurencja o miejsce w tkankach i na ich powierzchni, co może sprzyjać poprawie zdrowotności szparaga w uprawie polowej, ale głównie uwidacznia się po zbiorze. Zadowalające efekty związane z redukcją populacji bakterii na opłukiwanych wodą ozonowaną wypustkach szparaga uzyskano poprzez zwiększenie dawki ozonu do 2 ppm przy czasie 2 min lub poprzez wydłużenie czasu ekspozycji do 5 min przy stężeniu 1 ppm.
W obydwu badanych uprawach szparaga, w końcowych fazach wegetacji, na licznych roślinach zaobserwowano fazy uredinialne (fot. 5) i telialne (fot. 6) Puccinia asparagi. Rdza szparaga uznawana jest za najgroźniejszą chorobę badanego gatunku. Nie stwierdzono istotnych różnic pomiędzy kombinacjami doświadczenia. Zastosowanie do dezynfekcji ozonu spowodowało redukcję kolonizacji gałęziaków szparaga w Biskupicach przez bakterie w porównaniu do kontroli oraz oprysku pestycydami i w połączeniu z ozonem i biopestycydem. Nie stwierdzono również różnic pomiędzy liczbą szkodników glebowych w glebie podlewanej ozonem w porównaniu do kontroli (podlewanie wodą).
Badania wykonane w pakowalni w Poświętnie wykazały, że zastosowanie ozonowanej wody do dezynfekcji wypustek szparaga spowodowało zahamowanie wzrostu bakterii w porównaniu do prób kontrolnych. Woda ozonowana oddziałuje biobójczo na bakterie, w związku z czym zabieg przemywania wypustek sprzyjał ich trwałości podczas przechowywania. Również tempo starzenia się wypustek jest spowolnione, co przyczyniło się do dłuższego zachowania ich świeżości. Ozon w wodzie zwiększył ilość fruktozy i glukozy, błonnika oraz ilość substancji pożądanych w wypustkach, korzystnych dla zdrowia – polifenoli. Pozwoliło to na uzyskanie produktu o lepszych parametrach i podniosło przez to rynkową atrakcyjność szparaga. Płukanie wypustek w wodzie ozonowanej przez 5 i 10 min wpłynęło też na zwiększone wymywanie przylżeńców z wypustek podczas płukania, które są problemem dla plantatorów stosujących w uprawie podłoże popieczarkowe. W czasie przechowywania zakupionych od innych producentów szparagów zielonych i białych, największy ubytek masy zarejestrowano w kontroli. Po czterech dniach po zastosowaniu ozonowania ubytek masy wypustek zielonych był 2-krotnie mniejszy niż w kontroli, a po 11 dniach – średnio o ok. 42% mniejszy. Podobnie, ozonowanie spowodowało większą trwałość wypustek białych. Moczenie wypustek w wodzie ozonowanej wpłynęło na zmniejszone występowanie przylżeńców (fot. 7).
Badania laboratoryjne wykazały, że ozon w wyższych stężeniach >6 ppm może powodować fitotoksyczność roślin modelowych (bobu), choć nie wpływa bezpośrednio na śmiertelność mszyc (fot. 8), nie wpływa również na ich rozrodczość (fot. 9). Nie wykazał również istotnego wpływu na liczebność ziemiórek, ważnych szkodników glebowych (fot. 10), które występują na plantacjach szparaga, gdzie stosuje się podłoża popieczarkowe. Z badań laboratoryjnych nad szczepami referencyjnymi bakterii wynika, że woda ozonowana < 3 ppm ogranicza w wypustkach liczbę Gram-ujemnych bakterii i drożdży chorobotwórczych dla człowieka i tych związanych z roślinami (fot. 11). Woda ozonowana w małym stopniu ograniczała rozwój testowanych grzybów (fot. 12) Zabieg ozonowania nawet 10 ppm ozonu nie pogarsza jakości wypustek (fot. 13).

Fot. 1. Monitoring na polu szparaga w Garbcach w fazie wypustek

Fot. 2. Monitoring szkodników w Biskupicach

Fot. 3. Gałęziaki w Biskupicach

Fot. 4. Pole szparaga w Biskupicach po zabiegach z wykorzystaniem opryskiwacza polowego

Fot. 5. Uredinia rdzy szparaga

Fot. 6. Telia rdzy szparaga


Fot. 7. Analiza entomologoczna wypustek białych i zielonych po moczeniu w ozonowanej wodzie.


Fot.8. Testy w komorze w komorze opryskowej

Fot. 9. Ocena wpływu ozonu na mszyce – test szalkowy z liśćmi bobu

Fot. 10. Testy na szkodnikach glebowych
Fot. 11. Testy szalkowe na bakterie wykonane ozonatorem laboratoryjnym
Fot. 12. Testy szalkowe na grzyby wykonane ozonatorem laboratoryjnym

Fot. 13. Wypustki po ozonowaniu 10 ppm ozonatorem laboratoryjnym
W etapie IV Badania laboratoryjne wykazały, że ozon w wyższych stężeniach >6 ppm może powodować fitotoksyczność roślin modelowych (bobu), choć nie wpływa bezpośrednio na śmiertelność mszyc (fot. 8), nie wpływa również na ich rozrodczość (fot. 9). Nie wykazał również istotnego wpływu na liczebność ziemiórek, ważnych szkodników glebowych (fot. 10), które występują na plantacjach szparaga, gdzie stosuje się podłoża popieczarkowe. Z badań laboratoryjnych nad szczepami referencyjnymi bakterii wynika, że woda ozonowana < 3 ppm ogranicza w wypustkach liczbę Gram-ujemnych bakterii i drożdży chorobotwórczych dla człowieka i tych związanych z roślinami (fot. 11). Woda ozonowana w małym stopniu ograniczała rozwój testowanych grzybów (fot. 12) Zabieg ozonowania nawet 10 ppm ozonu nie pogarsza jakości wypustek (fot. 13).
Poniżej kilka zdjęć zakupionych środków trwałych.

Laweta z opryskiwaczem z instalacją do ozonowania wody

Beczka do przewozu wody

Wózek widłowy

Traktor